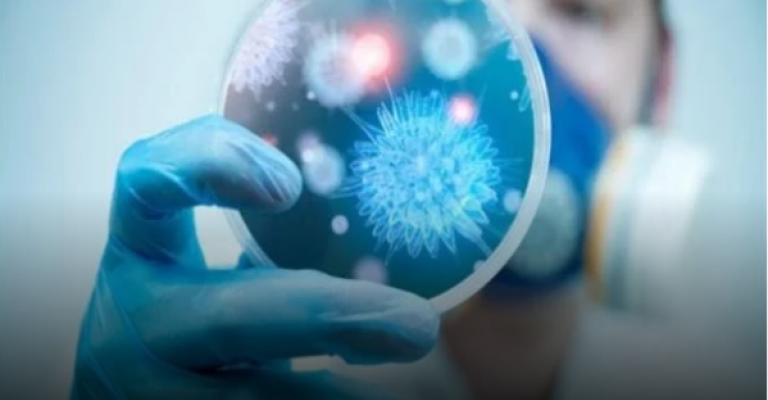

عمان نت

لقي سجينان مصرعهما، خلال أحداث شغب داخل سجن باب الهوا، في محافظة إربد (شمال)، بعد قرار منع الزيارات لمدة أسبوعين، كإجراء احترازي لمواجهة فيروس كورونا. وقال الناطق الإعلامي باسم الأمن العام الأردني، إن
قال وزير الصحة سعد جابر، الأحد، إنه يتم البحث حالياً عن فندق آخر للحجر الصحي، ليستضيف الأردنيين القادمين من بريطانيا، مضيفاً أن قدرة الأردن على الحجر تتراوح بين 250 إلى 350 حالة. وذكر عبر برنامج "صوت

وجه رئيس الوزراء، الدكتور عمر الرزاز، الوزارات المختصة والأجهزة الأمنية باتخاذ التدابير والإجراءات اللازمة لضمان تطبيق القرارات الحكومية التي صدرت يوم أمس حول فيروس كورونا بصرامة، وذلك حفاظاً على صحة

قال الناطق الاعلامي باسم مديرية الامن العام ان فريق خاص من البحث الجنائي والذي تولى البحث عن الشخص الذي هرب من العزل الصحي داخل مستشفى الامير حمزة قد تمكن من تحديد مكان تواجده ومداهمته بعد اخذ

بين وزير الصحة سعد جابر الأحد، إن عدد الحالات المصابة حاليا بفيروس كورونا المستجد في الأردن ارتفع إلى 10. وإضاف جابر ان حالتين من الحالات الثلاث المصابة قد خالطت السائحة الامريكية بالإضافة لتسجيل حالة

أعلنت هيئة تنسيق مؤسسات المجتمع المدني "همم" عن تأييدها للإجراءات والتدابير التي اتخذتها الحكومة الأردنية للتصدي لفيروس كورونا. وقالت "همم" في بيان صادر عنها "نقف مع الحكومة وأجهزة الدولة لمواجهة هذه

أكدت شركة مصفاة البترول الاردنية أن المشتقات النفطية بجميع انواعها متوفرة لدى محطات الوقود، واسطوانات الغاز المنزلية لدى موزعي الغاز بجميع مناطق المملكة وبكميات كافية وآمنة. وقال الناطق الإعلامي باسم

قرر أمين عمان الدكتور يوسف الشواربة تخفيض نسبة دوام الوظائف الإدارية العاملة في المكاتب إلى 50% من عدد العاملين ، ووضع الترتيبات اللازمة بالتنسيق مع دائرة تكنولوجيا المعلومات لتكليف العاملين بالمهام

قال مساعد الامين العام في وزارة الصحة، مسؤول الرعاية الاولية الدكتور عدنان اسحق، إن الوزارة ارسلت فريقين لفحص عمال ورواد الفندق الذي اكتشف داخله اصابة 4 فرنسيين بفيروس كورونا. واضاف اسحق أن الفريقين

قال وزير التربية والتعليم تيسير النعيمي، خلال الإيجاز، إن تعليق دوام المدارس لا يعني توقف العملية التعليمية، مؤكدا أن تعليم الطلبة أولوية قصوى وسنضمن هذا الحق. وأكد النعيمي تفعيل منصة التعلم












































